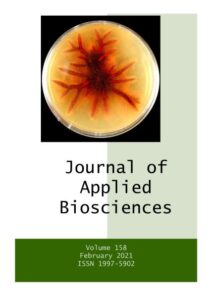

Journal of Applied Biosciences (JABs, J. Appl. Biosci.)
ISSN 1997 – 5902
DOI: 10.35759/JABs
Volume 201, October 2024
Plant Sciences
Boguinard Sahin Honorine Brigitte GUIRAUD, Gnion Mathias TAHI, Walet Pierre N’GUESSAN, Inago Caudou TREBISSOU, Klotioloma COULIBALY, Evelyne Maryse ASSI, Françoise GOGBE-DIBI, Acka Jacques Alain KOTAIX, Nobert N’Dri KOUAME & Kouamé François N’GUESSAN. Évaluation des performances agromorphologiques de clones de cacaoyers (Theobroma cacao L.) potentiellement haut producteurs et résistants au champ à la pourriture brune des cabosses en Côte d’Ivoire. [Read Abstract] [Download Full Paper-PDF]. https://doi.org/10.35759/JABs.201.1
Grévin Jean Achiédo AMBA, Souleymane DIOMANDÉ, Éric GNAHORÉ, Ali MANGARA, et Adama BAKAYOKO. Dynamique quantitative et variabilité floristique des adventices des vergers de cacaoyer (Theobroma cacao L.) dans le Département d’Adzopé au Sud-Est de la Côte d’Ivoire. [Read Abstract] [Download Full Paper-PDF] https://doi.org/10.35759/JABs.201.2
ZONGO Rodrigue Arnaud, NANA Rasmata, BERTHE Ousseni, SORY Aboubacar, BANHORO Aboulazize, KASSAMBA Diaby Hadi Abdoul. Effet des phytohormones sur la levée de dormance des semenceaux de Solenostemon rotundifolius [(Poir.) J. K. Morton]. [Read Abstract] [Download Full Paper-PDF] https://doi.org/10.35759/JABs.201.3
Kuan Abdoulaye TRAORE, Stéphanie GORA, Madou SANOU, Jean Bienvenue OUOBA, Lalidia Bruno OUOBA, WP Bertrand TIENDREBEOGO, Pierre ROQUES, Nicolas BARRO. Detection of hepatitis A virus (HAV) in fresh fruits, vegetable, wastewater and manure from irrigated farms in Ouagadougou, Burkina Faso. [Read Abstract] [Download Full Paper-PDF] https://doi.org/10.35759/JABs.201.4
GOMGNIMBOU Alain P.K., SANON A., COULIBALY K., SANOU Wilfried, DEMBELE B., FOFANA S., NACRO B. Hassan. Amélioration de la production de biomasse de Panicum maximum Jacq. C1 sous effets combinés de la densité des éclats de souches et de la fertilisation organo-minérale à l’ouest du Burkina Faso. [Read Abstract] [Download Full Paper-PDF] https://doi.org/10.35759/JABs.201.5
Malick NDIAYE, Eric CAVALLI, Anicet Georges Bruno MANGA, Tahir Abdoulaye DIOP. Mycorrhization improves the mineral nutrition of Sterculia setigera plants growing on Zinc-contaminated soil. [Read Abstract] [Download Full Paper-PDF] https://doi.org/10.35759/JABs.201.6
Ndonda Adrien, Bakelana Tony, Loko Kevine, Tevo Ndomateso, Tambu Evariste, Simon Ngongi, Constantine Manzenza, Mahungu Nzola. Fertilisation organo-minérale du manioc à base de Neptune’s HarvestTM à Mvuazi à l’Ouest de la République Démocratique du Congo. [Read Abstract] [Download Full Paper-PDF] https://doi.org/10.35759/JABs.201.7
Animal Sciences
Mungongo Mayama P, Thsikung Kambol M, Diafuka Saila N, Lufiaulusu Nzotuvuidi C, Kandu-Lelo Clement, Madimba Kapanga, Masuku Masky J and Malekani Mukulire J. Monitoring of nematodes hosted by endangered Bonobo (Pan paniscus Schwartz 1929) at Lola ya Bonobo Sanctuary (Kinshasa, DRC). [Read Abstract] [Download Full Paper-PDF] https://doi.org/10.35759/JABs.201.8
Médoune Sara KASSÉ, Bétémondji Désiré DIATTA, Mathieu GUEYE, Emeline HOUEL. Pathologies animales virales (fièvre aphteuse, clavelée) et traitements végétaux impliqués à Widou Thiengoly (Ferlo Nord). [Read Abstract] [Download Full Paper-PDF] https://doi.org/10.35759/JABs.201.9